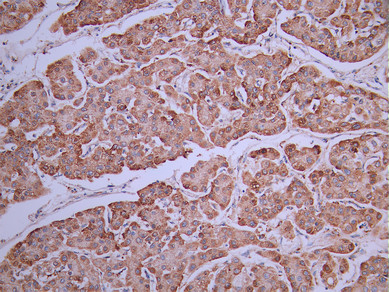

-
中文名稱:CPT2 Recombinant Monoclonal Antibody
-
貨號:CSB-RA118695A0HU
-
規格:¥1320
-
圖片:
-
IHC image of CSB-RA118695A0HU diluted at 1:100 and staining in paraffin-embedded human kidney tissue performed on a Leica BondTM system. After dewaxing and hydration, antigen retrieval was mediated by high pressure in a citrate buffer (pH 6.0). Section was blocked with 10% normal goat serum 30min at RT. Then primary antibody (1% BSA) was incubated at 4°C overnight. The primary is detected by a Goat anti-rabbit polymer IgG labeled by HRP and visualized using 0.05% DAB.
-
IHC image of CSB-RA118695A0HU diluted at 1:100 and staining in paraffin-embedded human liver cancer performed on a Leica BondTM system. After dewaxing and hydration, antigen retrieval was mediated by high pressure in a citrate buffer (pH 6.0). Section was blocked with 10% normal goat serum 30min at RT. Then primary antibody (1% BSA) was incubated at 4°C overnight. The primary is detected by a Goat anti-rabbit polymer IgG labeled by HRP and visualized using 0.05% DAB.
-
-
其他:
產品詳情
-
Uniprot No.:
-
基因名:
-
別名:Carnitine O palmitoyltransferase 2 antibody; Carnitine O palmitoyltransferase 2 mitochondrial antibody; Carnitine O-palmitoyltransferase 2 antibody; Carnitine palmitoyltransferase 2 antibody; Carnitine palmitoyltransferase II antibody; CPT 1 antibody; CPT 2 antibody; CPT II antibody; CPT1 antibody; CPT2 antibody; CPT2_HUMAN antibody; CPTASE antibody; CPTII antibody; IIAE4 antibody; mitochondrial antibody
-
反應種屬:Human
-
免疫原:A synthesized peptide from human CPT2 protein
-
免疫原種屬:Homo sapiens (Human)
-
標記方式:Non-conjugated
-
克隆類型:Monoclonal
-
抗體亞型:Rabbit IgG
-
純化方式:Affinity-chromatography
-
克隆號:11H5
-
濃度:It differs from different batches. Please contact us to confirm it.
-
保存緩沖液:Rabbit IgG in 10mM phosphate buffered saline , pH 7.4, 150mM sodium chloride, 0.05% BSA, 0.02% sodium azide and 50% glycerol.
-
產品提供形式:Liquid
-
應用范圍:ELISA, IHC
-
推薦稀釋比:
Application Recommended Dilution IHC 1:50-1:200 -
Protocols:
-
儲存條件:Upon receipt, store at -20°C or -80°C. Avoid repeated freeze.
-
貨期:Basically, we can dispatch the products out in 1-3 working days after receiving your orders. Delivery time maybe differs from different purchasing way or location, please kindly consult your local distributors for specific delivery time.
-
用途:For Research Use Only. Not for use in diagnostic or therapeutic procedures.
相關產品
靶點詳情
-
功能:Involved in the intramitochondrial synthesis of acylcarnitines from accumulated acyl-CoA metabolites. Reconverts acylcarnitines back into the respective acyl-CoA esters that can then undergo beta-oxidation, an essential step for the mitochondrial uptake of long-chain fatty acids and their subsequent beta-oxidation in the mitochondrion. Active with medium (C8-C12) and long-chain (C14-C18) acyl-CoA esters.
-
基因功能參考文獻:
- To the best of our knowledge, this is the first report of the coexistence of VHL disease and CPT2 deficiency in the same individual. Based on findings from animal models, the case illustrates that mutations in the VHL gene might protect against renal damage caused by CPT2 gene mutations. PMID: 27034144
- this study shows that upregulation of the citrate pathway and down-regulation of carnitine/acylcarnitine carrier gene in cells from children with Down syndrome PMID: 27502741
- The clinical presentation of patients with muscle carnitine palmitoyltransferase II deficiency is discussed in this review in line with enzymatic features. The thermolability of the mutant enzyme might explain why symptoms in muscle CPT II deficiency mainly occur during prolonged exercise, infections and exposure to cold. [review] PMID: 28054946
- Variations in AMPD1, CPT2, and PGYM genes are not associated with the onset, susceptibility, or severity of chronic fatigue syndrome. PMID: 27525900
- polymorphism may be associated with severity of EV71 infection PMID: 26874509
- CPT2 is active inside the mitochondrial matrix to recover acyl-CoA from a process generally known as the carnitine shuttle. This protein is expressed in a constitutive way in all cells and tissues. PMID: 26041663
- CPT II deficiency induces an energy crisis of the fatty acid metabolic pathway. PMID: 25781464
- L-carnitine deficiency participates in the pathogenesis of endometrial cancer by means of a mechanism which is unrelated with obesity and increased amount of fat in human body. PMID: 25335471
- The rs2229291 and rs1799821 variants in CPT II gene might be one of the predisposing factors of acute encephalitis. PMID: 25361188
- The F352C CPT2 variant might be a genetic risk factor for sudden unexpected death in infancy PMID: 23969168
- The data indicate that within the muscle form of CPT II deficiency, the various genotypes have only marginal influence on the clinical and biochemical phenotype. PMID: 24398345
- The present study shows that screening for second mutations in patients that are heterozygote for the common p.S113L is justified although rare symptomatic heterozygotes. PMID: 23475205
- The homozygous genotype (AA) of CPT2 variant V368I had significantly less blood carnitine in acute myocardial infarction patients. PMID: 23566841
- Allelic and phenotypic heterogeneity in 49 Italian patients with the muscle form of CPT-II deficiency PMID: 21913903
- CPT2 and CACT are crucial for mitochondrial acylcarnitine formation and export to the extracellular fluids in mitochondrial fatty acid beta-oxidation disorders. PMID: 23322164
- the thermolabile F352C CPT II variant, found only in Japanese, might be one of the predisposing factors to trigger the pathomechanism of acute encephalopathy in the Japanese population PMID: 21277129
- A homozygous mutation (c.534_558del25bpinsT) of CPT2 in a case of neonatal CPT II deficiency associated with Dandy-Walker syndrome and sudden death at 13 days of life. PMID: 21641254
- Data demonstrated the thermolabile CPT-II variants in demonstrated the thermolabile CPT-II variants in patients with viral infection-associated encephalopathy in Chinese population. PMID: 21697855
- Results revealed that having at least one carnitine palmitoyl transferase II CIM allele is a risk factor for the onset of acute encephalopathy, regardless of its antecedent infections. PMID: 20934285
- Analyzed potential rhabdomyolysis-susceptibility genes (RYR 1, CPT II, VLCAD and CYP 2D6) from autopsy samples of methamphetamine abusers; no obvious relationship between the genetic mutations observed in this study and rhabdomyolysis was seen. PMID: 20952238
- We found a high frequency of the common p.Ser113Leu mutation, the recurrence of the rare p.Arg631Cys mutation , and identified four novel mutations, in patients with muscle type CPT II deficiency. PMID: 20810031
- New allele (515del14)leads to a frameshift that results in a stop codon 15 codons upstream. PMID: 11855939
- genetic CPT II deficiency is characterized by insulin resistance, which is not explained by increased intramyomellular lipids. Homozygote. PMID: 11994355
- 5'-flanking region of this gene is transcriptionally active and binds PPARalpha , we characterized the peroxisome proliferator-responsive element in the proximal promoter of the CPT II gene, which appears to be a novel PPRE. PMID: 12408750
- 3 described mutations (S113L, P50H, & F448L) & two novel mutations (M214T & Y479F)OF cpt2 were modeled. A structure could be identified anchoring the protein in the membrane. Only Y479F is located within this region. PMID: 12707442
- Very high activity of CPT2 and VCLAD, involved in the metabolism of long-chain fatty acids. Fatty acid oxidation may play role in energy generation in placenta, and deficiency in may result in placental dysfunction and gestational complications. PMID: 12971426
- These results indicate that mutation of CPT II patient not to increase fatty acid oxidation during exercise. And also suggest that single CPT2 gene mutations may exert a dominant-negative effect on the tetrameric CPT II protein. PMID: 15622536
- The phenotype of muscle CPT II deficiency might be influenced by the underlying mutation,analysis of S113L ,P50H and Q413fs-F448L mutations PMID: 15642848
- A novel variant of CPT II was found in a patient with rhabdomyolysis & acute renal failure: a deletion of cytosine & thymine at codon 408, resulting in a stop signal at 420, & an Arg631Cys mutation. The frame shift at 408 has never been described before. PMID: 15754283
- A patient had an episode of acute renal failure with myoglobinuria, myalgias, and weakness. Carnitine palmitoyl-transferase II (CPT II) deficiency was documented both biochemically and genetically. PMID: 16168441
- In conclusion, the findings from this study indicate that exercise training alters the localization of FAT/CD36 and increases its association with CPT I, which may help augment fat oxidation. PMID: 16670153
- Within the CPT2 gene there were identified 16 novel deasese-causing mutations. PMID: 16996287
- acute overexpression of CPT I in muscle leads to a repartitioning of FAs away from esterification and toward oxidation and highlight the importance of CPT I in regulating muscle fatty acid metabolism. PMID: 17179390
- Our data evidenced that R631C mutation is not exclusively detected in the infantile form but it may be present in a wider spectrum of CPT2 phenotypes. These findings suggest that other modulators may influence clinical severity of CPT2 deficiency. PMID: 17651973
- We report a Japanese adult form of CPT II deficiency associated with a homozygous F383Y mutation causing myalgia and rhabdomyolysis. PMID: 17709715
- our data expand the spectrum of CPT II mutations and help to evaluate possible correlations between genotypes and phenotypes PMID: 17936304
- It was not possible to repair the CPT-2 gene under a variety of conditions, this approach is of little value until cellular DNA repair mechanisms are much better understood. PMID: 18024217
- unstable CPT II variants with decreased enzymatic activity may bring mitochondrial fuel utilization below the phenotypic threshold during high fever, and thus may play an important role in development of brain edema of influenza-associated encephalopathy PMID: 18306170
- study identified p.F383Y mutations in 6 of 7 Japanese patients with CPT II deficiency & 2 novel variants of the coding gene: p.Y408fsX420 & p.V605L; data suggest that the p.F383Y mutation is significant in Japanese patients with CPT II deficiency PMID: 18363739
- Two mutations in the CPT2 gene were identified in lethal neonatal or severe infantile diseases. PMID: 18550408
- The triheptanoin diet seems to be an effective therapy for adult-onset carnitine palmitoyltransferase II deficiency. PMID: 18645163
- Patient with adult-onset carnitine palmitoyl transferase II deficiency was able to have a successful pregnancy outcomes after fertilization in vitro. PMID: 19362304
- Case Report: Malignant hyperthermia-like syndrome and carnitine palmitoyltransferase II deficiency with heterozygous R503C mutation. PMID: 19762733
顯示更多
收起更多
-
相關疾病:Carnitine palmitoyltransferase 2 deficiency, myopathic, stress-induced (CPT2D); Carnitine palmitoyltransferase 2 deficiency, infantile (CPT2DI); Carnitine palmitoyltransferase 2 deficiency, lethal neonatal (CPT2DLN); Encephalopathy, acute, infection-induced, 4 (IIAE4)
-
亞細胞定位:Mitochondrion inner membrane; Peripheral membrane protein; Matrix side.
-
蛋白家族:Carnitine/choline acetyltransferase family
-
數據庫鏈接:
Most popular with customers
-
-
YWHAB Recombinant Monoclonal Antibody
Applications: ELISA, WB, IHC, IF, FC
Species Reactivity: Human, Mouse, Rat
-
-
-
-
-
-